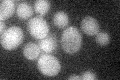
YEL069C

View description
Hexose transporter, induced in the presence of non-fermentable carbon sources, induced by low levels of glucose, repressed by high levels of glucose
Localization:
Intensity:
Fold change:
Significance:
-
C’ GFP library in SD
below threshold19.7 -
N' NOP1pr-GFP in SD

ER89.1745 -
N' TEF2pr-mCherry in SD

ER81.2561 -
N' NATIVEpr-GFP in SD

ER34.6008 -
N' TEF2pr-VC and Cyto-VN in SD

ER31.8824 -
C’ GFP library in SD+DTT

cytosol14.810.75No -
C’ GFP library in SD+H2O2

cytosol13.650.69No -
C’ GFP library in Starvation Media

cytosol15.040.76No -
C’ GFP library on the background of Pup2-DaMP

below threshold -
C’ GFP library on the background of CCT mutant

below threshold15.70590.796967No
